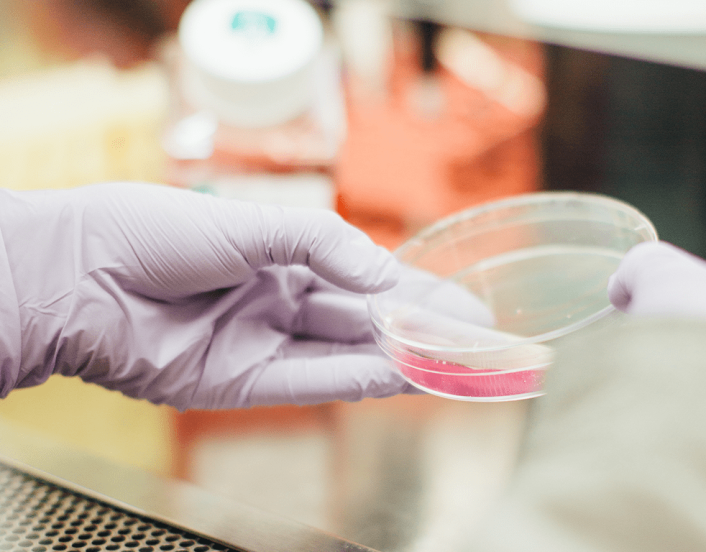
dermatalogypoc

Leading the Adoption and Commercialization of Canadian Health Innovation
Advancing Digital Health Innovation

DIGITAL is Canada’s commercialization partner for health transformation and industrial growth. We connect builders and buyers of Canadian technology and co‑invest in Canadian‑made digital solutions that improve patient outcomes, increase access to care, and help build sustainable healthcare systems in Canada and around the world.
Supported by leading research teams tackling the sector’s most urgent challenges, DIGITAL strengthens Canada’s health sovereignty and ensures care is delivered where it’s needed most. We have advanced the commercialization of data‑driven technologies, from AI‑powered diagnostics to remote patient monitoring and innovations that enhance care for older adults.
From Research to Global Deployment

DIGITAL is helping Canada shape the future of care by accelerating homegrown health technologies from research to global deployment. Focusing on projects that deliver immediate value, our proven model enables Canadian companies to validate health‑tech innovations in real clinical environments. With our Members and partners, DIGITAL is advancing the future of Canadian health innovation through:
- Connecting builders with buyers of Canadian health technology
- Opening doors to capital, talent, and global markets
- Building pathways into the digital economy
- Accelerating global commercialization while retaining Canadian IP
That’s how we grow Canada.
DIGITAL's Return on Canada's Investment
Since inception, DIGITAL has created billions in projected revenue opportunities for Canadian companies across sectors critical to Canada’s future. Our impact in the Health sector includes:
- $432M
- total investment in health projects. $182M of DIGITAL investment
- 435
- Canadian-owned health IP assets anchored in Canada
- 122
- commercial health and wellness products or services scaling globally
- 79
- unique healthcare projects
As of September 2025
Health Tech in Action
We support the development of health technology solutions for Canada. These Portfolio Highlights demonstrate the strength of our collaborative model and the measurable outcomes our Members deliver globally. View all Health projects >>
See our portfolio highlights below.
-

Health
Advanced AI Wound Care NetworkSupporting AI enhancements for better & more equitable access to quality wound care.
-

Health
AI Patients for Experimental Healthcare TrainingPioneering healthcare interactive training through AI and extended reality.
-
Health
Dermatology Point-of-Care Intelligent NetworkAI-powered medical imaging network to connect all points of care for patients who may be dealing with skin cancer.
-

Health
XrAIAI-powered lung diagnostics deployed in rural BC, SK, and ON—approved by Health Canada.
-

Health
Postoperative Patient Management Platform (PPMP)Using AI to proactively deliver personalized patient care through early detection and intervention.
The DIGITAL Experience
-

“Brightshores involvement in the DITGIAL-funded project has introduced an AI tool into our rural community that has transformed wound assessment methods and documentation processes while supported limited human health resources. Furthermore, our involvement in this consortium has fostered a strong network of partners across the nation who are striving in solidarity to tackle the burden of wounds our communities experience.”
Director, Research & Innovation, Brightshores Health System. -

“At WELL Health, we are committed to leveraging technology to empower healthcare providers and reduce burnout by equipping them with responsible AI and other tools to assist in providing quality care and ultimately improve patient outcomes. “Projects like Health Compass II directly support this mission and are essential in fuelling healthcare’s digital transformation.”
Chairman and CEO of WELL Health Technologies Corp.
CONNECT WITH US
Jesse Coleman, PhD
Health Portfolio Manager
As DIGITAL’s Health Portfolio Manager, Jesse is dedicated to accelerating the adoption of Canadian health technology. He leverages over 15 years of experience in clinical research, implementation, and evaluation to help members navigate the complex path to market. Having guided medical device companies through critical regulatory landscapes (including Health Canada and the FDA) and scaled national initiatives, Jesse provides the strategic oversight SMEs need to accelerate market entry and sustainable commercial success.
Contact us below or connect with Jesse on LinkedIn.
Let's Connect














